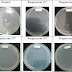

Setiap politik yang di anut oleh setiap negara pasti memiliki kelebihan dan kelemahan.Begitu pula dengan sistem politik yang dianut oleh Indonesia yang memiliki sisi kelebihan dan kekurangan.
Ada beberapa kelebihan dari sistem politik yang di anut Indonesia antara lain:
- a. Warga negara bisa terlibat dalam hal-hal tertentu seperti pembuatan keputusan-keputusan politik,baik secara langsung maupun melalui wakil-wakil yang mereka pilih.
- b. Warga negara memiliki kebebasan atau kemerdekaan menyangkut hak-hak kebebasan yang telah mencakup dalam hak asasi manusia (seperti hak politik,ekonomi,kesetaraan di depan hokum dan pemerintahan,ekspresi kebudayaan,dan hak pribadi).
- c. Masyarakat yang telah memenuhi syarat tertentu memiliki hak untuk berpartisipasi dalam pemilihan pemerintahan (pemilu).
- p Penduduk memilih secara rahasia tanpa ada unsure paksaan.
- e. Pengambilan keputusan di lakukan dengan cara bermusyawarah untuk mencapai mufakat.
- f. Mengutamakan persatuan nasional dan kekeluargaan.
Kelemahan-kelemahan dari sistem politik yang di anut Indonesia antara lain:
- a. Terjadi konflik diantara masyarakat,apabila mereka terlibat dalam hal politik yang sama dan memiliki pandangan yang berbeda.
- b. Dengan adanya kebebasan untuk mengemukakan pendapat,maka masyarakat sewenang-wenang mengeluarkan isi hatinya,meskipun bersifat negative yang biasanya di tujukan kepada pemerintah yang kurang di senangi.
- c. Belum mampu menjamin keadilan distributive,karena hakikat politik yang memberikan peluang arena bersaing.
- d. Proses kemajuan ekonomi yang sudah di capai selama ini akan beratakan,karena pemerintah kewalahan dalam melaksanakan kepemimpinannya karena adanya perbedaan suku,bahasa,dll.yang menyebabkan prinsip mereka juga berbeda.